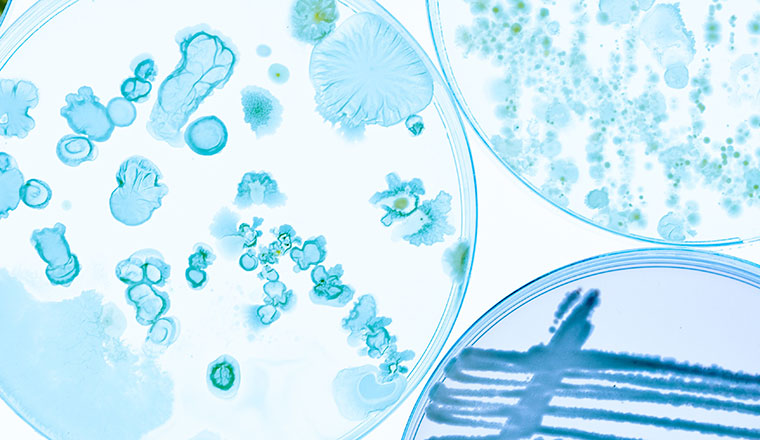
microbiology2_760x440px

Bakery and confectionery
Trusted analytical support for consistent quality in every batch
From ingredient sourcing to final packaging, quality and consistency are key to the bakery and confectionery industry. Eurofins Food & Feed testing and consultancy services help you manage complex recipes, control allergens, meet labelling requirements, and maintain shelf life, all while keeping up with evolving food safety standards.
Key services
- Targeted allergen and contaminant testing to ensure ingredient integrity
- Microbiological analysis to support freshness and shelf stability
- Nutritional testing and label verification to provide regulatory confidence
- Shelf-life studies to support product development and reduce waste
Eurofins Food & Feed laboratories analyse all kinds of baked goods and sweet treats, including bread, rolls, muffins, cakes, biscuits, pastries, pies, brownies, chocolate bars, candies, gummies, chewing gum, toffees and marshmallows, as well as sugar-free and functional sweets, honey and sugars.